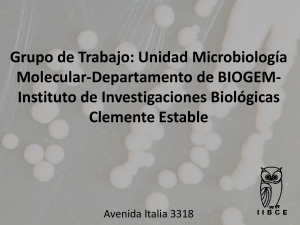
PRESENTACION DEL GRUPO DE TRABAJO LINEAS DE TRABAJO

Levadura

Se denomina levadura o fermento a cualquiera de los diversos organismos eucariotas, clasificados como hongos microscópicos unicelulares, que son importantes por su capacidad para realizar la descomposición mediante fermentación de diversos cuerpos orgánicos, principalmente los azúcares o hidratos de carbono, produciendo distintas sustancias.Aunque en algunos textos de botánica se considera que las levaduras «verdaderas» pertenecen solo a la clase Ascomycota, desde una perspectiva microbiológica se ha denominado levadura a todos los hongos con predominio de una fase unicelular en su ciclo de vida, incluyendo a los hongos basidiomicetes.A veces suelen estar unidos entre sí formando cadenas. Producen enzimas capaces de descomponer diversos sustratos, principalmente los azúcares. Una de las levaduras más conocidas es la especie Saccharomyces cerevisiae. Esta levadura tiene la facultad de crecer en forma anaerobia realizando fermentación alcohólica. Por esta razón se emplea en muchos procesos de fermentación industrial, de forma similar a la levadura química, por ejemplo en la producción de cerveza, vino, hidromiel, aguol, pan, antibióticos, etc.Las levaduras se reproducen asexualmente por gemación o brotación y sexualmente mediante ascosporas o basidioesporas. Durante la reproducción asexual, una nueva yema surge de la levadura madre cuando se dan las condiciones adecuadas, tras lo cual la yema se separa de la madre al alcanzar un tamaño adulto. En condiciones de escasez de nutrientes las levaduras que son capaces de reproducirse sexualmente formarán ascosporas. Las levaduras que no son capaces de recorrer el ciclo sexual completo se clasifican dentro del género Candida.La levadura es la primera célula eucariota en la que se ha intentado expresar proteínas recombinantes, debido a que es de fácil uso industrial: es barata, cultivarla es sencillo y se duplica cada 90 minutos en condiciones nutritivas favorables. Además, es un organismo fácil de modificar genéticamente, lo que permite realizar experimentos en varios días o semanas. Sin embargo, las levaduras poseen un mecanismo de glicosilación diferente al que se encuentra en células humanas, por lo que los productos son inmunogénicos.